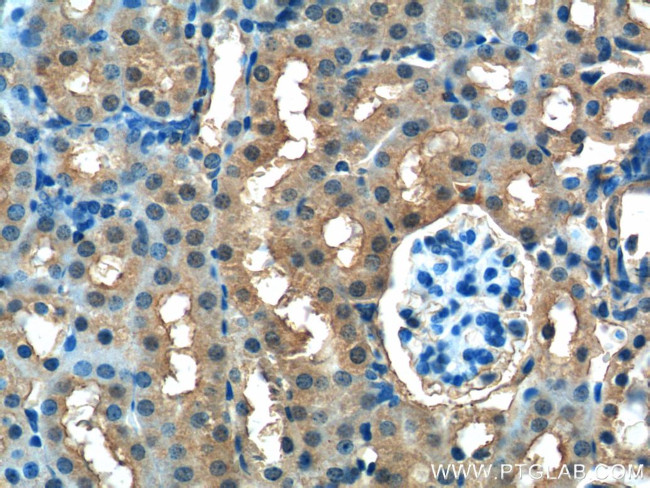
FUK Antibody in Immunohistochemistry (Paraffin) (IHC (P))
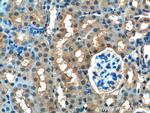
FUK Antibody in Immunohistochemistry (Paraffin) (IHC (P))

Search
Proteintech
FUK Polyclonal Antibody
{{$productOrderCtrl.translations['antibody.pdp.commerceCard.promotion.promotions']}}
{{$productOrderCtrl.translations['antibody.pdp.commerceCard.promotion.viewpromo']}}
{{$productOrderCtrl.translations['antibody.pdp.commerceCard.promotion.promocode']}}: {{promo.promoCode}} {{promo.promoTitle}} {{promo.promoDescription}}. {{$productOrderCtrl.translations['antibody.pdp.commerceCard.promotion.learnmore']}}
产品信息
13541-1-AP
种属反应
宿主/亚型
分类
类型
抗原
偶联物
形式
浓度
规格
纯化类型
保存液
内含物
保存条件
运输条件
产品详细信息
Immunogen sequence: TEQVELPGP GQWVVAECPA RVDFSGGWSD TPPLAYELGG AVLGLAVRVD GRRPIGARAR RIPEPELWLA VGPRQDEMTV KIVCRCLADL RDYCQPHAPG ALLKAAFICA GIVHVHSELQ LSEQLLRTFG GGFELHTWSE LPHGSGLGTS SILAGTALAA LQRAAGRVVG TEALIHAVLH LEQVLTTGGG WQDQVGGLMP GIKVGRSRAQ LPLKVEVEEV TVPEGFVQKL NDHLLLVYTG KTRLARNLLQ DVLRSWYARL PAVVQNAHSL VRQTEECAEG FRQGSLPLLG QCLTSYWEQK KLMAPGCEPL TVRRMMDVLA PHVHGQSLAG AGGGGFLYLL TKEPQQKEAL EAVLAKTEGL GNYSIHLVEV DTQGLSLKLL GTEASTCCPF P (695-1084 aa encoded by BC032542)
靶标信息
The protein encoded by this gene belongs to the GHMP (galacto-, homoserine, mevalonate and phosphomevalonate) kinase family and catalyzes the phosphorylation of L-fucose to form beta-L-fucose 1-phosphate. This enzyme catalyzes the first step in the utilization of free L-fucose in glycoprotein and glycolipid synthesis. L-fucose may be important in mediating a number of cell-cell interactions such as blood group antigen recognition, inflammation, and metastatis. While several transcript variants may exist for this gene, the full-length nature of only one has been described to date.
仅用于科研。不用于诊断过程。未经明确授权不得转售。
篇参考文献 (0)
生物信息学
蛋白别名: Fucokinase; L-fucose kinase; mFLJ00241 protein; unnamed protein product; UNQ5838
基因别名: 1110046B12Rik; AI303278; CDGF2; FCSK; FUK
UniProt ID: (Human) Q8N0W3, (Mouse) Q7TMC8
Entrez Gene ID: (Human) 197258, (Mouse) 234730, (Rat) 307848